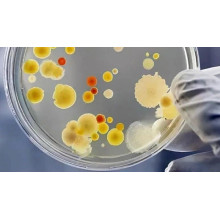

- Home
- About us
- Products
- Lab fermenter(SS316, 5L-50L)
- Industry fermenter(1KL-400KL)
- Mammalian cell bioreactor(5L-10KL)
- Lab Fermenter Bioreactor Industrial Stainless Steel Fermenter
- Vaccine Fermenter(GMP) Fermentation Equipment stainless Steel Bioreactor
- Mini Lab Glass Fermenter Magnetic Mixing Cell Culture Fermenter Bioreactor
- CIP Station Automatic Bioreactor Fermenter
- Faqs
- News
- Certificate
- Contact us
-
Collagen is the most abundant protein in the human body
time2025/09/05
-
When it comes to semaglutide, the first reaction of most people is to become a popular "weight loss miracle drug" on their social media
time2025/09/08
-
As the core equipment of biotechnology, the production and operation details of bioreactors directly affect production efficiency and product quality
time2025/09/09
-
Cardiovascular disease is the leading cause of death worldwide, resulting in nearly 21 million deaths annually.
time2025/09/10
-
In the field of biomanufacturing, successful processes in the laboratory
time2025/09/11
-
The Ministry of Industry and Information Technology recently released the "Guidelines for Cultivating Pilot Service Platforms for Biological Manufacturing (Draft for Comments)"
time2025/09/12
-
In the operation and maintenance of industrial steam equipment, the selection of drain valves and the control of welding residual stress are two inseparable matters.
time2025/09/15
-
Summarize the core of biological reactions and fermentation control in one sentence
time2025/09/16
-
In the fields of biopharmaceuticals, cell therapy, enzyme catalysis, etc., bioreactors are the core equipment for achieving efficient biotransformation.
time2025/09/17
-
In the big health industry, "liquid fermentation" is a key technology for revitalizing traditional Chinese medicine.
time2025/09/18
-
Multiple bioreactors from Bailun have appeared in the news reports!
time2025/09/19
-
The core of fermented traditional Chinese medicine is "using microorganisms as tools and traditional Chinese medicine ingredients as substrates", and the differences in ingredients of different traditional Chinese medicines determine the selection of bacterial strains.
time2025/09/22
-
High performance bacterial strains are the key to the industrialization of biomanufacturing.
time2025/09/23
-
I want to know about the "dual effect hypoglycemic and weight reducing drug" semaglutide (the core ingredient of Ozempic and Wegovy)
time2025/09/24
-
Hyaluronic acid (HA), also known as hyaluronic acid
time2025/09/25
-
Hangzhou first submitted a form to the Hong Kong Stock Exchange for Dahua Biotechnology, aiming to become the first stock in weight management for the Hong Kong stock market
time2025/09/26
-
Astaxanthin is a high-value terpene antioxidant, with natural sources including algae, yeast, and marine organisms.
time2025/09/29
-
Ministry of Industry and Information Technology announced the list of iconic products in the field of biomanufacturing
time2025/09/30
-
When 'liquid gold' meets synthetic biology.
time2025/10/01
-
Precision fermentation as an emerging biomanufacturing technology
time2025/10/02
-
In the medical beauty and health industry, biological reaction strains are widely used in raw material production, skincare product research and development, and medical scenarios through technologies such as biological fermentation and metabolic regulation.
time2025/10/03
-
GLP-1 drugs have become "star drugs" due to their dual effects of sugar control and weight loss
time2025/10/06
-
The human gut is home to billions of microorganisms, which not only assist digestion but also regulate core physiological processes such as immunity and metabolism through molecular signals. Their imbalance is closely related to various diseases.
time2025/10/07
-
Recently, many people have been posting NMN on their social media, claiming to be the "anti-aging tool" and "anti-aging treasure".
time2025/10/08
-
When it comes to semaglutide, the first reaction of most people is to become a popular "weight loss miracle drug" on social media - it has become a "hot commodity" in the fitness and beauty circles due to its significant weight loss effect.
time2025/10/09
-
In 1992, American scientists accidentally discovered a peptide called "GLP-1" in the venom of the Gila lizard, a species of venomous lizard that lives in the deserts of North America. This substance can effectively stimulate insulin secretion and lower blood sugar.
time2025/10/10
-
The dietary supplement market in the United States is undergoing a transformation centered around "biological activity".
time2025/10/13
-
To understand this year's Nobel Prize, we need to first understand why the immune system "hits its own people"?
time2025/10/14
-
Fermentation experiment of L-threonine production by Escherichia coli using different stirring combinations
time2025/10/15
-
AI+automation - the future path of bioreactors: from precision fermentation to smart pharmaceuticals
After the discovery of penicillin in 1928, it was almost useless due to difficulties in mass production. It was not until 1944 that deep tank fermentation technology realized its large-scale production - the core value of bioreactors, which has always revolved around "achieving target product scale more efficiently".
time2025/10/16
-
How to evaluate the accuracy of fermentation? You can refer to the following indicators.
time2025/10/17
-
Huang He, academician of the CAE Member, pointed out at the 17th China Bioindustry Conference
time2025/10/20
-
In the first half of 2025, Novo Nordisk achieved strong performance with its Simeglutide series products.
time2025/10/21
-
It can be understood as a new industrial revolution, with its core features being greener, more efficient, and more sustainable
time2025/10/22
-
Chen Jian, an academician of the CAE Member and a professor of Jiangnan University, made a judgment at the 2025 annual meeting of China's fragrance essence cosmetics industry
time2025/10/23
-
Bailun Biology: This' Chinese jar 'is rapidly moving towards the world
time2025/10/24
-
These industries are gaining momentum and will create a new high-tech industry in China in the next 10 years
time2025/10/27
-
The difference in yield between fermenter fermentation and shake flask fermentation is influenced by various factors, and the magnitude of the difference varies depending on the specific situation.
time2025/10/28
-
Solid state fermentation refers to a biotechnology process that utilizes the metabolic activities of microorganisms (such as fungi, bacteria, yeast, etc.) to achieve substance transformation in a solid matrix with almost no free flowing water.
time2025/10/29
-
Mechanical seals, as a key component in preventing medium leakage in rotating equipment, have a direct impact on the stability and safety of the equipment during operation.
time2025/10/30